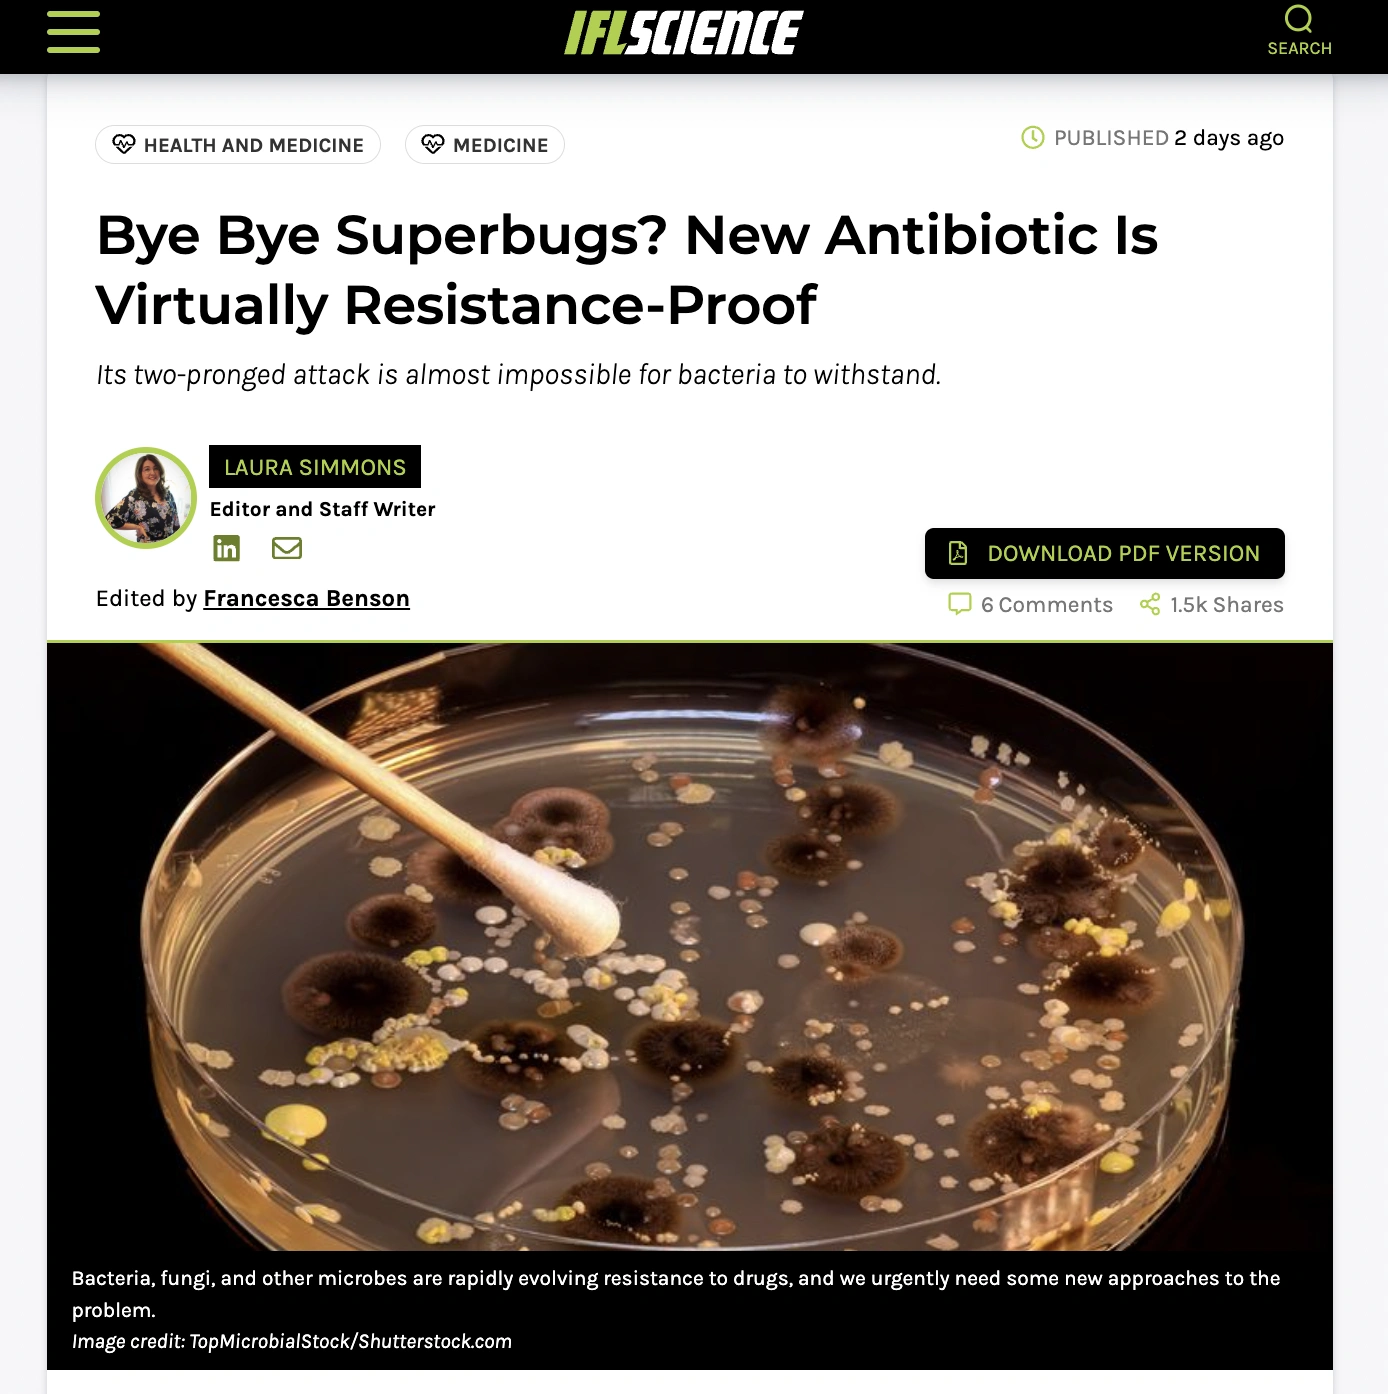

20 Futuristic Technologies Propelling us Towards the Singularity
While some fear that artificial intelligence is taking over the world and causing the downfall of the internet and job market, not all technological advancements are negative. In recent years, scientists have made significant breakthroughs that could either lead us to a bright future or a dystopian society. From carbon-based margarine that tastes like real butter to a drug that regrows teeth, these 20 sci-fi tech advances are propelling us towards a future that is both exciting and uncertain.